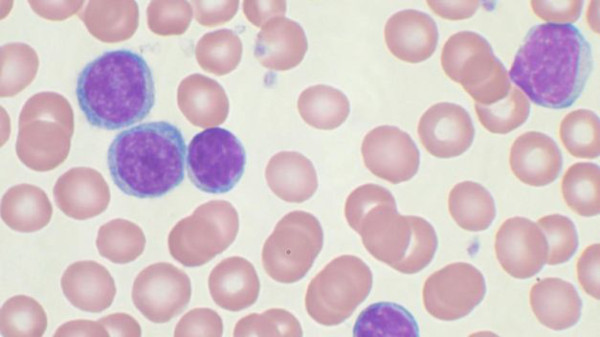
Las células madre del cordón umbilical pueden ayudar a pacientes con leucemia

El cultivo en laboratorio de células madre tomadas de la sangre en el cordón umbilical puede mejorar significativamente la supervivencia de los pacientes con leucemia, según un anuncio hecho hoy por la Universidad Loyola.
Los científicos del Centro Médico Cardinal Bernardin de esa universidad en Illinois presentaron los resultados de su estudio en la reunión anual de la Sociedad Estadounidense de Hematología en Nueva Orleans.
La sangre donada del cordón umbilical contiene células madre que pueden salvar las vidas de los pacientes con leucemia, linfoma y otros tipos de cáncer de la sangre.
Patrick Stiff, autor principal del estudio, indicó que la tecnología de expansión celular puede incrementar el número de pacientes a quienes beneficien los trasplantes de células madre derivadas del cordón umbilical.
Los cánceres que afectan a la producción y a la función de las células de la sangre, en su mayoría, comienzan en la médula ósea donde se produce la sangre.
Normalmente las células madre en la médula ósea maduran y se desarrollan en tres tipos de células sanguíneas: las células rojas, las células blancas y las plaquetas.
En la mayoría de los cánceres de la sangre un crecimiento descontrolado de un tipo anormal de células sanguíneas interrumpe el proceso normal de desarrollo de las células de la sangre.
Estas células anormales impiden que la sangre desempeñe muchas de sus funciones como el combate de las infecciones o la prevención de las hemorragias graves.
Según el estudio, los trasplantes de células madre pueden salvar la vida de los pacientes a quienes ya no les quedan otras opciones de tratamiento.
Los pacientes con cáncer reciben altas dosis de quimioterapia y, a veces, también altas dosis de radiación. Estos tratamientos matan las células rojas de la sangre junto con las células cancerosas y, para reconstituir las reservas de células madre, a los pacientes se les trasplanta una infusión de células madre que todavía no han madurado.
Con el tiempo estas células madre se desarrollan como nuevas células sanguíneas.
Las células madre producidas en la médula ósea a menudo provienen de miembros de la familia del paciente u otros donantes que se han registrado para hacer la contribución.
Pero, señaló el estudio, menos del 50 por ciento de los pacientes elegibles para un trasplante puede encontrar un donante de médula ósea compatible, y en tales casos las células madre derivadas de la sangre del cordón umbilical puede ser una alternativa eficaz, ya que no requiere una compatibilidad perfecta.
Estas células madre provienen de donaciones de familias de recién nacidos y se preservan congeladas en un banco de sangre de cordón umbilical.
Cada una de estas donaciones consiste, habitualmente, en unos 30 mililitros de sangre, lo cual es suficiente apenas para un niño o un adulto pequeño, pero muchos adultos deben recibir una dosis doble que provienen de dos donantes.
El estudio que dirigió Stiff examinó una tecnología nueva, registrada con el nombre comercial de StemEx, mediante la cual se cultivan las células madre de la sangre del cordón umbilical en un laboratorio y después de 21 días se incrementa hasta en 14 veces el número de células disponibles para trasplante.
El estudio incluyó veinticinco centros en Estados Unidos, Israel y Europa en los cuales se empleó la tecnología con 101 pacientes con leucemia y linfoma. Los resultados con estos pacientes se compararon con un grupo de control de 295 pacientes que habían recibido una dosis doble de células madre de la sangre del cordón umbilical.
Después de cien días la tasa general de supervivencia resultó significativamente más alta (84,2 por ciento) que la del grupo de control (74,6 por ciento). EFE
Las células madre del cordón umbilical pueden ayudar a pacientes con leucemia
Los cánceres que afectan a la producción y a la función de las células de la sangre
- Actualizado: 09 dic 2013 /
Washington,Estados Unidos